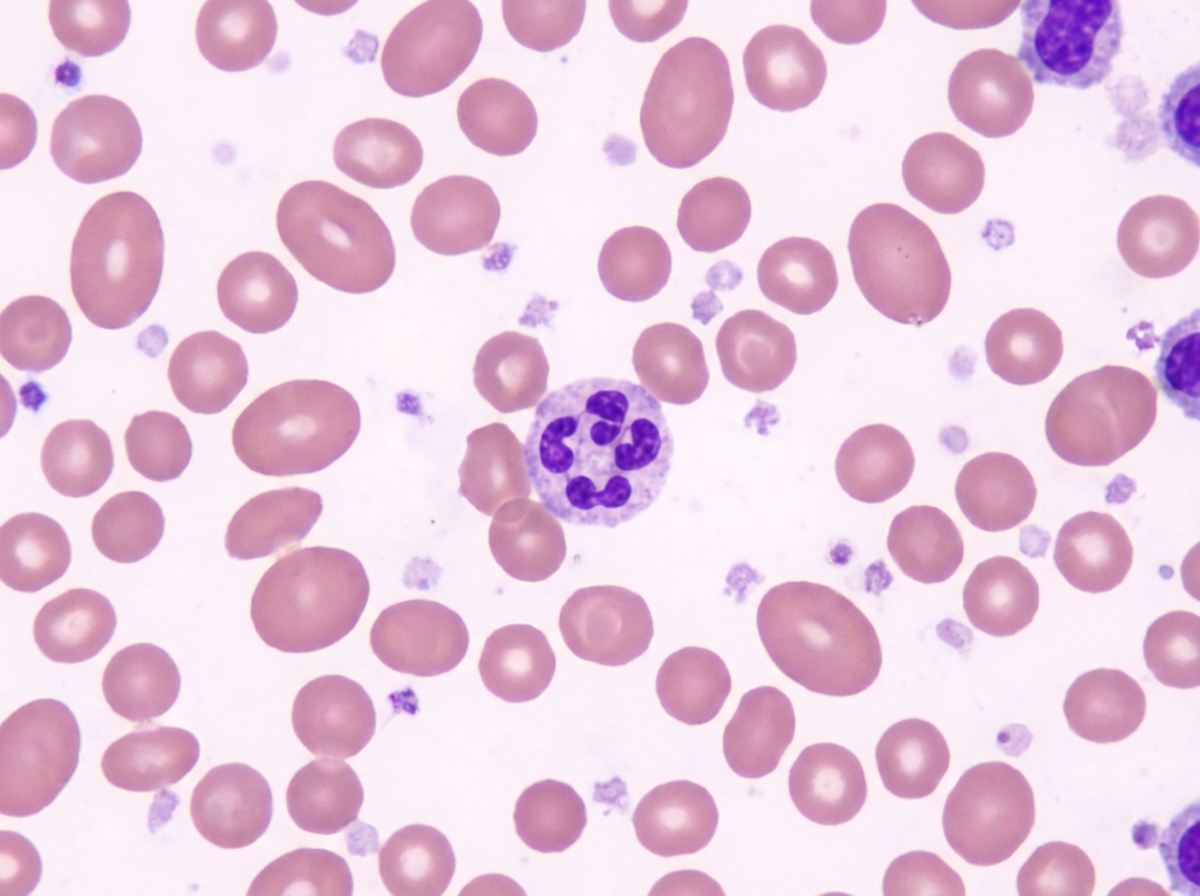
Image for question 389

Enter your email to get your 85% OFF code and unlock the full NEET PG question bank on the app.
Hemophilia B is due to deficiency of which clotting factor?
Which of the following statements regarding umbilical cord banking is FALSE?
The type of non-Hodgkin's lymphoma with the highest rate of gastrointestinal system involvement is:
Pancytopenia with a cellular bone marrow is seen in all of the following conditions except:
The Coombs test is used for diagnosing which of the following conditions?
Factor IX deficiency results in increased which of the following?
Burkitt's lymphoma is positive for which CD marker?
Blast crises in Chronic Myeloid Leukemia (CML) are characterized by which of the following?
Comment on the type of anemia observed in a peripheral smear.
Defect leading to thalassemia lies in which component?
Anemias: Classification and Approach
Practice Questions
Hemolytic Anemias
Practice Questions
Myeloproliferative Neoplasms
Practice Questions
Myelodysplastic Syndromes
Practice Questions
Acute Leukemias
Practice Questions
Chronic Leukemias
Practice Questions
Lymphomas and Lymphoid Neoplasms
Practice Questions
Plasma Cell Disorders
Practice Questions
Bleeding Disorders
Practice Questions
Thrombotic Disorders
Practice Questions
Get full access to all questions, explanations, and performance tracking.
Scan to download app